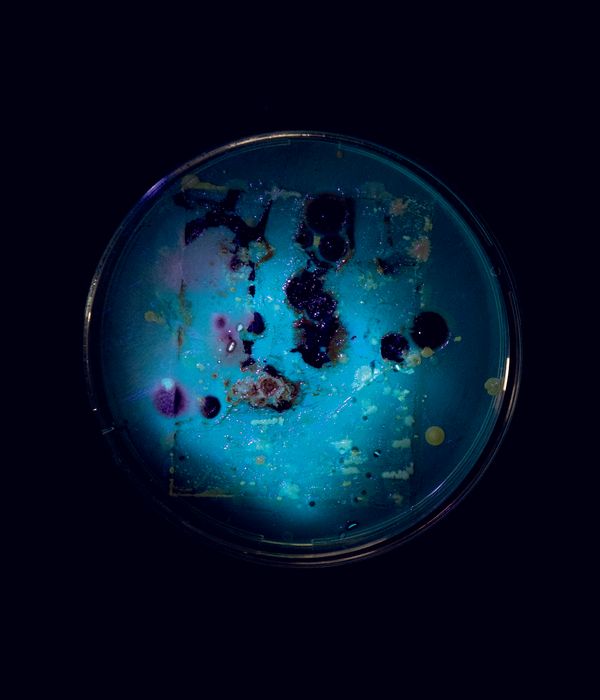

Planet Agar Agar
-
Dates2019 - 2020
-
Author
The project Planet Agar Agar tells the story of a celestial body discovered during an interstellar journey. A planet covered with mold and fungi, continuously evolving life forms. The narrative alternates imagination and reality, microscopic and macroscopic, intertwining biology and photography. The objective is direct: to deconstruct the photographic image, leaving only traces of pictures, like a lost novel broken into fragments. These signs release the observers from the need of understanding what is real and what is not, therefore allowing them to roam free on the obscure ground of the planet; a field where document and imagination, pixel and pigment, biology and technology are fused together. The action of time is fundamental – the time of traveling, the cultivation of bacteria, the slow destruction of the photographic picture, and the collection of these images. Eventually, Agar Agar becomes the land where bacteria win over animal life.